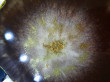
Отзыв на Блестки декоративные «Золото» (5 г) от Марина Вячеславовна

Выдумщики Блестки декоративные «Золото» (5 г)В данный момент этот товар отсутствует в продаже. Возможно, у нас найдется аналогичный или похожий товар здесь. Блестки станут нарядным дополнением к мылу ручной работы. Украсят любой кусочек мыла, придав ему немного мягкой элегантности или кричащего гламура. Выбор за вами! |
Выдумщики, Россия, все товары
Блёстки использовала для эпоксидной смолы. Нужно сыпать поменьше, я немного переборщила. А так очень понравились, лёгкие и красиво поблёскивают.
Без сюрпризов. Блестки меленькие, цвет соответствует заявленному. Не понравилось только, что банка заполнена на четверть, то есть тара подобрана не по объему, ну то такое, заметки перфекциониста.

Б лёстки - Очень Мелкие.
Размер аночки НЕ соответствует весу спродукта. т.е. баночка намного больше - Самого продукта, - очень мало, он, почти, на донышке.
Купила блёстки для рукоделия, но продукта в баночке очень мало. 5 грамм - да, за такую цену! Дороговато! из- за этого сняла 2 звезды.